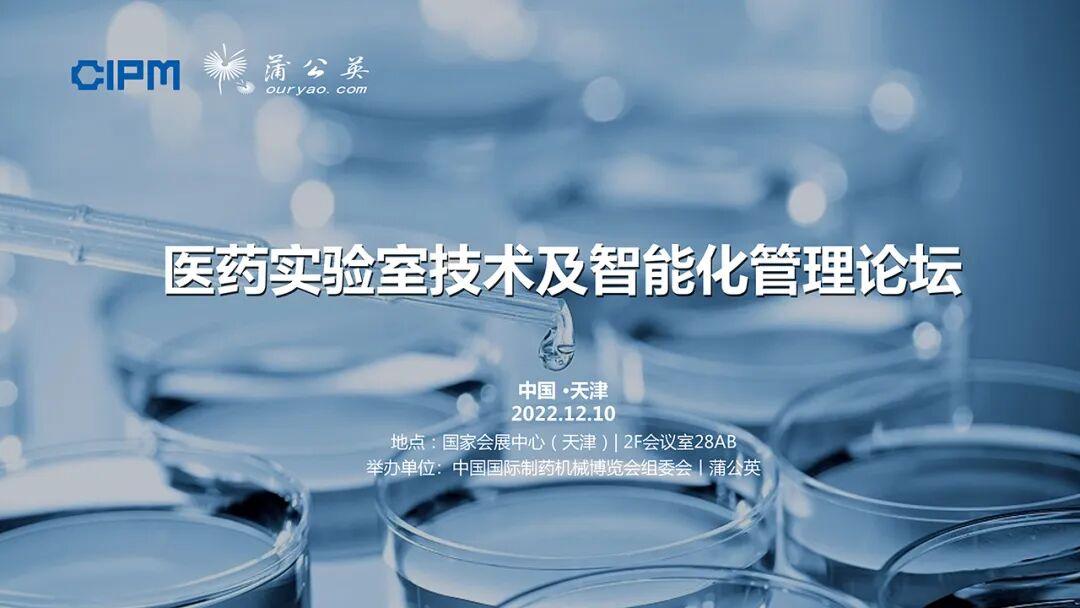

第62届(2022年秋季)全国制药机械博览会暨2022(秋季)中国国际制药机械博览会(以下简称“药机博览会”)将于2022年12月9日至11日在国家会展中心(天津)举办。伴随着全球经济形势的深刻变化,创新技术的碰撞融合,医药产业格局也在不断的调整。制药产业所面临的创新升级、可持续发展的时代需求,给广大制药人提出了新的课题和挑战。本届博览会期间组委会精心策划了五场主题论坛,聚焦行业热点赛道的发展布局、传统产业的创新升级、制药装备领域的绿色环保及数智化之路,邀请众多国内外行业专家和企业家分享趋势洞见,把握产业脉搏,共赴行业新时代。论坛将采取现场会议同步网络直播形式。 










2021年秋季博览会论坛现场(左右滑动)
生物制药论坛2022.12.9-12.10
国家会展中心(天津)二层会议室27AB
举办单位:中国国际制药机械博览会组委会

随着全球生物制药技术的快速发展和市场需求的持续增长,我国已成为全球第二大生物医药市场,生物制药产业也步入发展的快车道。在全球疫情及国际贸易严峻形势的冲击下,从需求、供给、政策层面,都给国内生物制药上游耗材及装备国产化创造了新一轮的发展机遇。如何抓住难得的行业高速发展窗口期,洞悉前沿技术风向,深入解读国内外法规,积极布局产业链赛道,是众多企业面临的共同课题。继去年CIPM首次成功举办生物制药论坛,今年组委会特别邀请了国内外生物制药领域的知名专家学者、产业界领军人物,围绕生物制药行业趋势,热点技术和产业化应用,探讨新形势下产业突破与升级的机遇与挑战,助力我国生物制药行业的高质量发展。
*论坛所有议程以现场为主
口服固体制剂论坛2022.12.9-12.10
国家会展中心(天津) 二层会议室32AB
举办单位:中国国际制药机械博览会组委会

随着我国医疗卫生水平不断提高和药品需求量不断加大,对于制药生产过程的要求也越来越高。在一致性评价的不断推进、政策法规趋严以及成本不断攀升的背景下,口服固体制剂生产企业和设备制造企业都面临着药品产能提升、质量合规、新药开发以及制药设备升级等方面的严峻挑战。针对口服固体制剂生产过程的工艺难点、工艺与设备的关系、新工艺新技术的展望等行业所关注的热点,CIPM举办口服固体制剂论坛,邀请了多位制药行业的资深专家,多角度分享国内外制药行业设备的先进技术和工艺设计解决方案,以促进口服固体制剂行业的发展。
*论坛所有议程以现场为主
医药实验室技术及智能化管理论坛2022.12.10
国家会展中心(天津)二层会议室28AB
举办单位:中国国际制药机械博览会组委会丨蒲公英
2022年国家发布了“十四五”国家药品安全及促进高质量发展规划,提高企业质量标准和检验能力的建设,加快企业信息化和智能化建设,是规划中的重点工作内容。不断提升实验室技术水平,推进智能化管理,也是十四五期间医药产业实验室的重要工作。
本次论坛由中国国际制药机械博览会组委会联合蒲公英共同举办,聚焦实验室技术及智能化管理的主要环节和要素,为广大制药企业的实验室管理提升提供借鉴。
*论坛所有议程以现场为主
绿色智能-制药工厂建设新生态论坛2022.12.9-12.10
国家会展中心(天津)二层会议室31AB
举办单位:中国国际制药机械博览会组委会丨中国电子系统工程第四建设有限公司
协办单位:上海计然碳科技有限公司

本次“绿色 智能—制药工厂建设新生态”论坛由CIPM组委会与中国电子系统工程第四建设有限公司联合举办。绿色环保是人类面临的共同挑战和选择,碳达峰、碳中和的目标也与每一个工业企业息息相关,在“双碳”目标成为共识的今天,将引发一场面向未来新高地的争夺。谁掌握了更高水平的减排手段,谁更早实现碳中和,谁就能建立更负责任的企业形象,具备更大的行业影响力和更广泛的国际竞争力,同时也彰显出企业更强的技术实力。本次论坛旨在进一步推动我国制药工程设计、建设水平的快速发展,全面提升为国家制药工厂提供的保障能力,聚焦绿色制药工厂的设计、智能化建造、运维管理,全流程多角度对我国制药工厂的建设进行研讨。
*论坛所有议程以现场为主
制药数字化与信息化论坛2022.12.10
国家会展中心(天津)二层会议室29AB
举办单位:中国国际制药机械博览会组委会丨天俱时工程科技集团有限公司

当前,数字技术正在以各种新理念、新业态、新模式全面融入制药行业,通过智能制造实现制药生产环节的可视、可控和智能化,不仅可以减少人工偏差,确保操作流程的合规性和信息透明度,从而保证药品生产质量,降低生产成本;还可以通过数据分析整合持续改进药品质量与企业管理水平,数字化转型已经成为制药行业谋求创新的发展大势,成为制药企业重塑核心竞争力的必然选择。本次论坛由中国国际制药机械博览会组委会和天俱时工程科技集团有限公司举办,将围绕国家政策、前沿探索、热点话题、技术应用、典型案例等内容进行专业的交流分享,共同探究制药行业设计、研发、生产、质量、验证等新形态中的数字化转型应用以及众多实践案例,共话制药数字化与信息化发展之路。
*论坛所有议程以现场为主
论坛观众报名通道现场参会请扫描二维码我们诚邀您共赴天津,探索制药产业发展新格局,共同迎接行业新时代!
论坛咨询张可子 18513981603Email: zhangkezi@phmacn.com刘烁 18513981078 Email: liushuo@phmacn.com